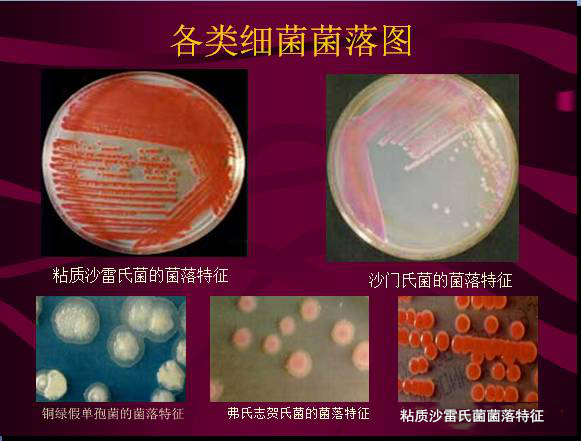
常見微生物菌落形態(tài)及消毒滅菌方式(圖4)
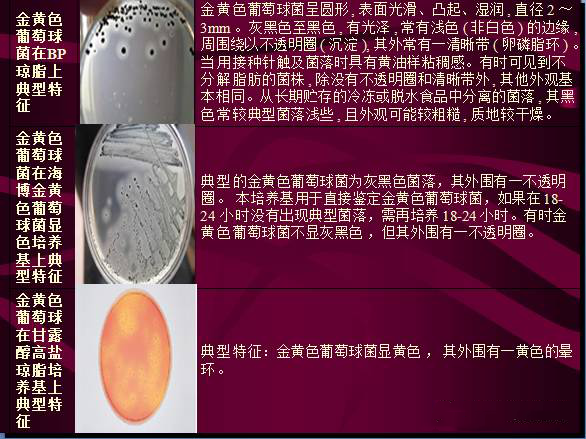
常見微生物菌落形態(tài)及消毒滅菌方式(圖5)
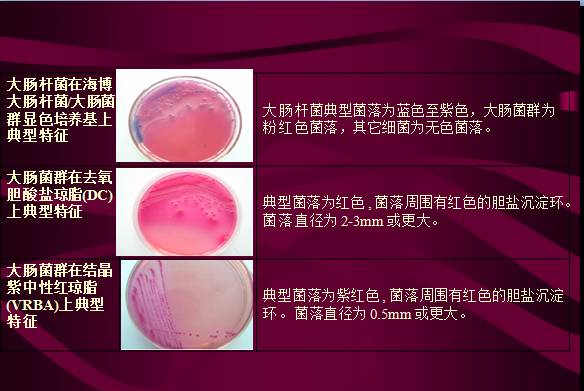
常見微生物菌落形態(tài)及消毒滅菌方式(圖6)
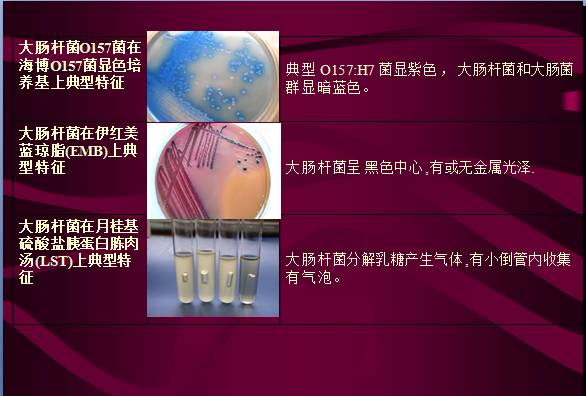
常見微生物菌落形態(tài)及消毒滅菌方式(圖7)
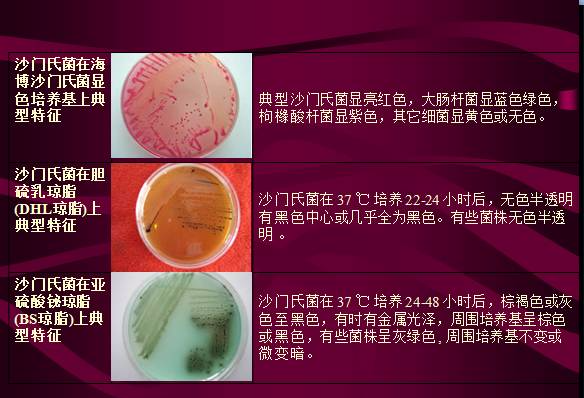
常見微生物菌落形態(tài)及消毒滅菌方式(圖8)
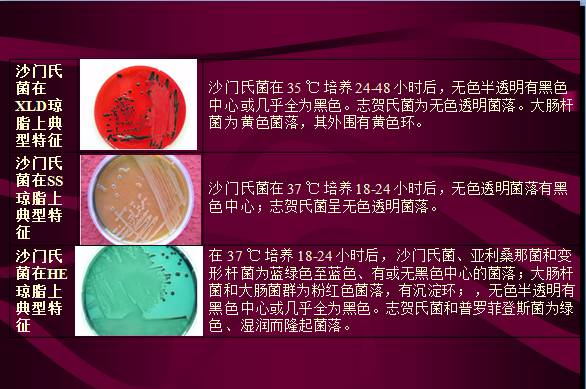
常見微生物菌落形態(tài)及消毒滅菌方式(圖9)
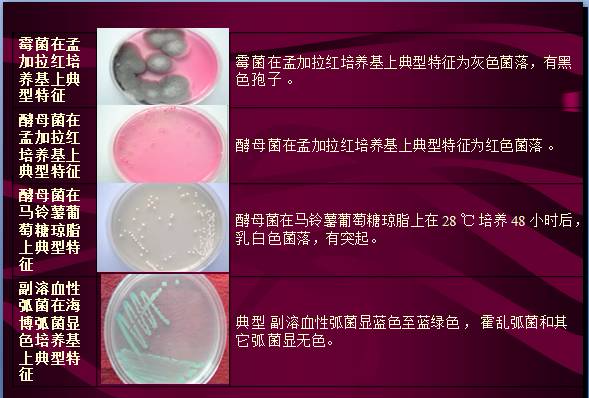
常見微生物菌落形態(tài)及消毒滅菌方式(圖10)
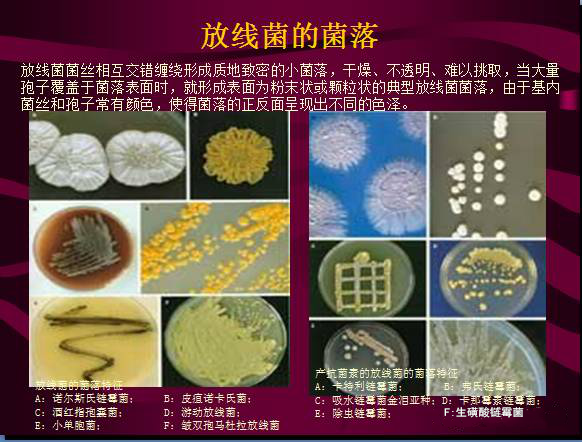
常見微生物菌落形態(tài)及消毒滅菌方式(圖15)
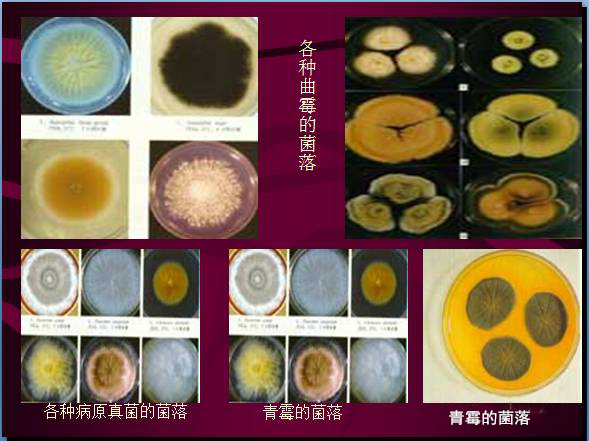
常見微生物菌落形態(tài)及消毒滅菌方式(圖17)

常見微生物菌落形態(tài)及消毒滅菌方式,這是很多有關(guān)消毒和感控人都想了解的,我們具體給大家歸類了一些常見的微生物菌落形態(tài)及常見消毒滅菌方式,希望能更多的幫助到大家,這是信點(diǎn)醫(yī)療小編整理的一些關(guān)于常見微生物及消毒滅菌方式的詳細(xì)內(nèi)容,供大家參考。
我們現(xiàn)在已經(jīng)知道的微生物有十萬種左右,微生物在土壤中的數(shù)量最多,據(jù)統(tǒng)計(jì),一克土壤中......,以下是介紹詳細(xì)內(nèi)容,歡迎大家覽閱。

銷售服務(wù)熱線:400-029-2090
公司總臺(tái)電話:400-029-2090轉(zhuǎn)4
售后服務(wù)專線:400-029-2090轉(zhuǎn)3 17316607625(微信同號(hào))
官方郵箱地址:xd@xindianmedical.com
官方微信公眾號(hào):XD83336449(或公眾號(hào)搜索“信點(diǎn)醫(yī)療”)
公司營(yíng)銷中心地址:中國(guó)?西安高新區(qū)高新一路25號(hào)創(chuàng)新大廈N701-703室